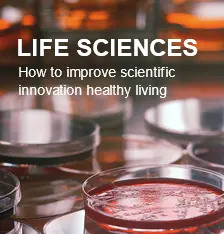

Tel:717-5587307
Email:sales@Kernelkits.com
Our Science and technology solutions |
Our Mission |
|
Constituents, Dairy Testing, Equipment, Industrial Contaminants, Microbiology, Pesticides, Toxins and Veterinary Drugs
|
Constituents, Dairy Testing, Equipment, Industrial Contaminants, Microbiology, Pesticides, Toxins and Veterinary Drugs
|
Analytical Food Testing, Research Services and Custom Development of Detection Assays
|
About Us
We focus our expertise to discover, develop and market innovative diagnostic solutions for major farm animal diseases,Food and Feed Analysis to protect consumer health. As a world leader in farm animal diagnostics, we are committed to providing our customers with high-quality products and sustainable solutions.
Our Kernel food tests can be used to verify mycotoxins, hormones, antibiotics, risk material, allergens or pathogen germs in a fast, reliable and above all economically efficient fashion. These test systems have become indispensable for many companies in the food processing industry and their quality control departments. More>> |
Latest press releases
-
Biologists against X-ray method to study the impact of cesium swept worry
Since the FBI began checking all want to study mice Margaret Goodell immunology lab person must submit a bunch of security programs.
2019-06-24
-
New Bluetongue Test to Help India's Poor Improve Livestock Productivity
Researchers at The Pirbright Institute have developed field tests for Indian strains of bluetongue virus (BTV) that are reliable, rapid and simple to use.
2019-06-24
-
G20 Challenged to Fight Antibiotic Resistance
RUMA chair Gwyn Jones says it is hoped the article will place some much-needed context around the role of medicines in livestock farming.
2019-06-24
-
Inexpensive, more humane FMD test for pigs developed
Scientists at the Pirbright Institute in the UK found a new way to diagnose foot-and-mouth disease (FMD) in pigs and other animals.
2019-06-24
-
Antibiotic-Resistant Bacteria Found in UK Supermarket Chicken, Pork
Scientists at the Pirbright Institute in the UK found a new way to diagnose foot-and-mouth disease (FMD) in pigs and other animals.
2019-06-24
-
Case of Scrapie in North Iceland
A case of scrapie has been confirmed at a farm in Skagafjoerour. Scrapie is a fatal, degenerative disease, which affects the nervous systems of sheep and goats.
2019-06-24
-
Vitamin D Could Help Control Bovine TB in Wild Animal Hosts
The pilot study of 40 animals was conducted by a multidisciplinary team of scientists from the University of Surrey (UK), Universidad de Extremadura (Spain), and SME Ingulados (Spain).
2019-06-24
-
H5N8 avian influenza detected in France
An outbreak of H5N8 bird flu has been detected on a duck farm in France, the French Ministry of Agriculture reports. The ducks of the infected holding will be slaughtered.
2019-06-24
-
Hong Kong limits its Brazilian meat import ban
Since March 21, a total of 66 samples were taken at import and retail levels for testing of meat deterioration and other food safety indicators (such as metallic contaminants).
2019-06-24
-
Colombia: the main pig producing region could be declared free of CSF
The WOAH's Scientific Commission for Animal Diseases, once having assessed the results of the audit visit to Colombia, acknowledged that the area including the regions of Choco, Caldas, Quind铆o
2019-06-24
-
Europe sweats as swine fever threat goes global
Previously confined to the European part of Russia and the Baltic states, the spread of African swine fever (ASF) further east and west is causing alarm on a global scale.
2019-06-23
-
Kazakhstan declared foot-and-mouth-disease free
First Deputy Minister of Agriculture of Kazakhstan Kairat Aituganov said at a press briefing at the government that OIE delegates from 180 countries unanimously voted to assign this status to Kazakhstan at the session of the organisation’s General Assembly in Paris. He stressed this became possible
2019-06-23